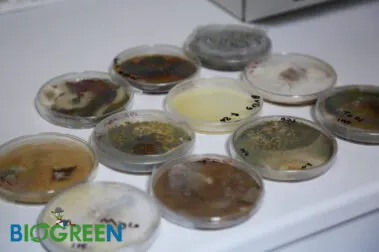
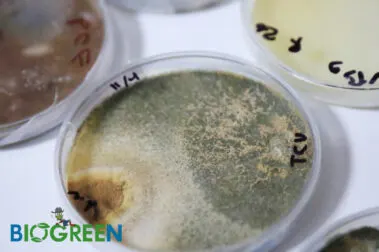

2015’den beri…
Biogreen Tarım Biyolojik Mücadele Sistemleri Ltd. Şti. 2015 yılında Antalya’da faaliyetlerine başlayıp, zirai bitki koruma ürünleri, bitki köklendirici ve bitki geliştirici sıvı gübreler ve çiftçilerin ihtiyaç duyabileceği yardımcı ürünler ile yurt içi ve dünya çapında çiftçilere destek sunmaktadır.
Özellikle Asya ülkeleri, Orta Doğu ve Avrupa ülkeleri başta olmak üzere, yapışkan rulo tuzaklar, kart tipi tuzaklar, delta tipi tuzaklar, feromonlar (tuta absoluta, thrips, cydia pomonella vb.) bombus arısı ve diğer organik ürünler ile insan sağlığı için faydalı olan her ürünü tarımın gelecekte her zaman ki gibi daha da önem kazanacağını ve insan sağlığı için yapılan her işin daha faydalı olacağını düşüncesi ile laboratuvar ve saha ekibimiz ile birlikte yararlı işler yapmaya devam etmektedir.
Çalışmalarımız sonucunda elde ettiğimiz ürünler ile üreticinin ürün kaybının azalması ve kalitesinin yükselmesi neticesinde ülkelerin değerlerine ve topraklarına artı kazanımlar sağlamaktadır. Dünyanın değişik coğrafyalarında tarımı yapılan bitkilerin zirai mücadelesi ve bitki geliştirici ürünler ile gelişiminin hızlandırılması ve üretim kapasitesinin artmasına olanaklar sunmaktadır.
Saygılarımızla
Biogreen Tarım Biyolojik Mücadele Sistemleri Ltd. Şti